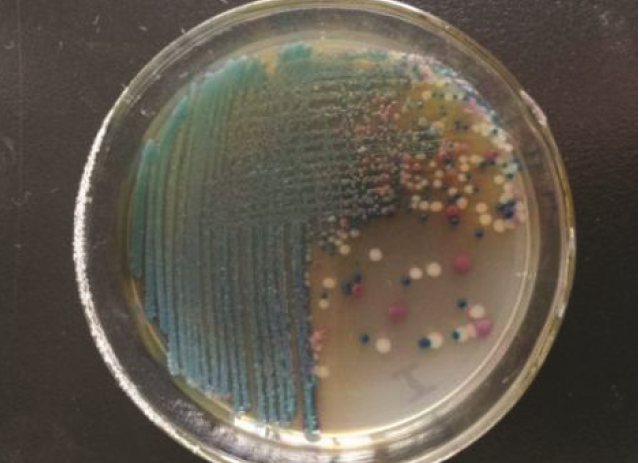
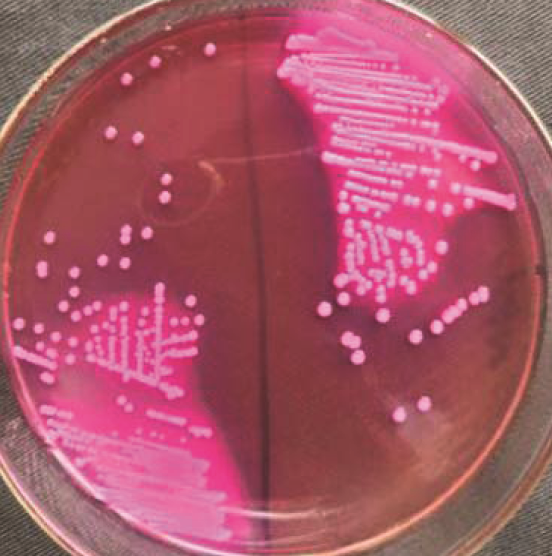

0 引言
【研究意义】呼吸系统疾病是鸡的一类多发性疾病,其发病原因复杂,治疗效果差,给养鸡业造成巨大的经济损失。【前人研究进展】以呼吸极度困难为主要症状的呼吸系统疾病,主要表现为鸡的一侧或者双侧支气管有黄白色干酪样物质栓塞[1,2,3]。有文献显示因支气管堵塞死亡500多只鸡[4],以及死鸡剖检后在支气管与所管分叉处的气管环处有明显拴塞物[5]。【本研究切入点】鸡支气管堵塞死鸡病不能确定其发病原因[6]。鸡支气管堵塞的发病原因较多,患鸡肺和支气管的纤维素样堵塞均是由H9亚型禽流感或鸡传染性支气管炎等病毒病引起的,并多伴有支原体或大肠杆菌的继发感染[7]。鸡呼吸道堵塞的形成与环境因素关系较大,H9亚型禽流感、传染性喉气管炎、传染性支气管炎、禽曲霉菌病及沙门氏菌病等都有可能参与这种病变的形成[8]。【拟解决的关键问题】针对支气管堵塞病例,用常规细菌分离法和结合16 sDNA测序进行细菌学分析。研究支气管堵塞形成过程中细菌的作用,为兽医临床防控和治疗该类疾病提供依据。
1 材料与方法
1.1 材料
1.1.1 动物及病料
健康昆明系小白鼠,18~25 g/只,54只,购自新疆医科大学实验动物中心。
无菌截取约0.8~1 cm的气管末端典型病变组织,置于4 mL Ep管中,低温保存,及时进行细菌学分析。图1
图1
图1
支气管内的堵塞物
注:(a)支气管末端分叉处有中空的黄色干酪样堵塞物充满管腔;(b)管腔内取出的堵塞物
Fig.1
The endobronchial blockage
Note: (a) Hollow yellow cheese-like obstruction at the bifurcation of the end of the bronchus filled with obstruction;(b) removed from the lumen of the official cavity
1.1.2 试剂仪器及引物
试剂:麦康凯琼脂(MAC)、叠氮钠-结晶紫-七叶苷琼脂、Mueller-Hinton琼脂(以下简称MH),购自北京鼎国昌盛生物技术有限责任公司。鸡支原体培养基、法国科玛嘉尿路菌群显色培养基(CHROMagar)、脑心浸出液肉汤(Brain Heart Infusion Broth BHI),药敏纸片:头孢噻肟(CTX 30 μg)、头孢他啶(CAZ 30 μg)、庆大霉素(CN 10 μg)、阿米卡星(AN 30 μg)、四环素(TE 30 μg)、氨苄西林(Amp 10 μg)、环丙沙星(CIP 5 μg)、左氧氟沙星(LEV 5 μg)、氯霉素(CHL 30 μg)、氨曲南(AZT 30 μg)、复方新诺明(SMZ 23.75 μg),细菌微量生化鉴定管购自青岛高科技工业园海博生物技术有限公司。5%绵羊血平板,自制。PCR反应相关试剂(2×Taq PCR Green Mix、ddH2O),购自上海生工生物工程技术服务有限公司。
自动高压灭菌锅(HVE-50),离心机(Eppendorf AG 22331 Hamburg),空气浴振荡培养箱(ST-F160AC),TProfessional PCR 仪Biometra公司产品;凝胶成像系统为Universal Hood ll Bio-Rad公司产品。Eppendorf Mastercycler nexus GSX1 PCR仪;DYY-7C型电泳仪(北京市六一仪器厂)。
引物合成:参照文献选择引物,由上海生工生物工程股份有限公司合成。表1
表1 引物基本信息
Table 1
| 引物名称 Primer name | 引物序列 Primer sequences (5'→3') | 目的片段 Product length/bp |
|---|---|---|
| 大肠杆菌 Escherichia coli | F:5'-ATCC TGGC TCAG ATTG AACG CT-3' R:5'-TACA AGGC CCGG GAAC GTAT TCA-3' | 1 439 bp[9] |
| 粪肠球菌 Enterococcus faecalis | F:5'-TGCC GCAT GGCA TAAG AG-3' R:5'-TGCA TCAC CTCG CGGT CTAG-3' | 1 271 bp[10] |
| 16S rDNA | 27F:AGAGTTTGATCCTGGCTCAG 1492R:CGGTTACCTTGTTACGACTTC | 1 500 bp[11] |
| 鸡毒支原体MG Mycoplasma gallisepticum | F:5'-GGATCCCATCTCGACCAGGAGAAAA-3' R:5'-CTTTCAATCAGTGAGTAACTGATGA-3' | 732 bp[12] |
| 滑液支原体MS Mycoplasma synoviae | F:5'-GAAGCAAAATAGTGATATCA-3' R:5'-GTCGTCTCGAAGTTAACAA-3' | 207 bp[12] |
1.2 方法
1.2.1 细菌分离培养
将病料置于支原体液体培养基和BHI液体培养基中,在37℃恒温培养箱中分别培养1~7 d和24 h。支原体液体培养基在培养过程中观察的颜色变化。将BHI菌液划线接种科马嘉显色培养基,于37℃培养24 h,将不同形态、大小、色泽和湿润度的菌落分别划线接种5%绵羊血平板进行纯化培养。
1.2.2 PCR和生化鉴定
1.2.3 药敏试验
按Kirby-Bauer法,用MH培养基进行药敏试验。菌液制备用MH液体培养基稀释菌株到0.5麦氏浊度,用灭菌的棉拭子蘸取菌液均匀涂布在90 mm培养基表面,开盖静置3~5 min后用镊子夹取药敏片放置在培养基上,贴好后静置15 min后于37℃恒温培养箱倒置培养24 h。用大肠杆菌ATCC 25922作质控菌株,判定标准按美国 NCCLS 操作标准[14]。
1.2.4 小鼠致病性试验
挑取纯化的单菌落接种于无菌EC肉汤中培养12~18 h,使用分光光度计测定OD600 nm,将培养过后的菌液稀释,并将OD600 nm固定到1。取体重为20~25 g雌性昆明小白鼠禁食不禁水12 h后,随机分为3组,每组18只,分别为大肠杆菌菌株试验组、粪肠球菌菌株试验组、空白对照组。试验组小鼠腹腔注射菌液,0.3 mL/只,对照组注射同剂量无菌生理盐水。隔离饲养,研究小白鼠的临床症状,死亡后剖检,观察病变并采集小鼠脾脏和肝脏培养和镜检。
2 结果与分析
2.1 细菌分离鉴定
研究表明,11个鸡场(A-K)共采集了18份样本。综合样本信息,A、B、C、D、E、L鸡场于6月发病,F场发病于7月发病,G、H鸡场于8月发病,I、J鸡场发病于9月,K鸡场于12月发病。每个鸡场收集样本1份,其中J场收集了8份样本。
图2
表2 菌株培养特性
Table 2
| 菌株 Strains | 科马嘉尿路显色培养基生长状况 Growth status of CHROMagarTM | 绵羊血平板生长状况 Growth status of sheep blood plate | 镜检结果 Microscopic examination results |
|---|---|---|---|
| 1类菌 Class 1 bacteria | 紫红色,不透明,边缘整齐表面光滑。 | 灰白色,半透明,边缘整齐表面光滑,γ溶血,直径2~3 mm。 | 革兰氏阴性短杆菌,两端重染呈哑铃状 |
| 2类菌 Class 2 bacteria | 深蓝色菌落,不透明,边缘整齐表面光滑。 | 灰白色,不透明,边缘整齐表面光滑,γ溶血,直径0.5~1 mm。 | 革兰氏染色不明显,镜下为小的椭圆形,个别呈短链状排列。 |
| 3类菌 Class 3 bacteria | 白色菌落,不透明,体积较大,无扩散迁徙的现象。 | 灰白色,不透明,边缘不整齐,呈散射状迁徙生长,γ溶血。 | 革兰氏阴性杆菌 |
| 4类菌 Class 4 bacteria | 奶油色菌落,不透明 | 灰白色,不透明,边缘整齐,表面光滑,γ溶血,直径1~2 mm。 | 革兰氏染色不明显,镜检短杆状或球状 |
4种菌的DNA模板经16S rDNA扩增后测序,结果1类菌与大肠杆菌同源性达99%~100%;2类菌与粪肠球菌同源性达96%~100%;3类菌与奇异变形杆菌同源性为97%;4类菌与鲍曼不动杆菌同源性为93%。
1类菌在MAC培养基上为粉红色菌落,用大肠杆菌特异性引物进行扩增,均在1 439 bp处出现目的条带;2类菌在叠氮钠-结晶紫-七叶苷琼脂上为褐色菌落,菌落周围变黑,进行粪肠球菌的特异性扩增,所有该类菌均在1 271 bp处出现目的条带。图3~6
图3
图4
图4
2类菌在叠氮钠-结晶紫-七叶苷琼脂上呈褐色菌落
Fig.4
The second kinds of bacteria showed Brown colony on sodium azide-crystal violet-aescin agar
图5
图5
MAC培养基上粉红色单菌用大肠杆菌通用引物PCR扩增
注:1~20:样本,21:阴性,M:2 000 Maker
Fig.5
Amplification results of pink single bacteria on MAC medium by E. coli universal primer PCR
Note: 1-20: samples, 21: negative, M: 2,000 Maker
图6
图6
叠氮钠-结晶紫-七叶苷琼脂上长褐色菌落用粪肠球菌特异性引物PCR扩增
注:1~19:样本,泳道20:阴性对照,M:2 000 Maker
Fig.6
Amplification results of Enterococcus faecalis specific primers on sodium azide-crystal violet-aescin agar by PCR
Note: 1-19: samples, swimming lane 20: negative control, M:2,000 Maker
研究表明,1类菌吲哚阳性,MR阳性,VP阴性,丙二酸盐阴性,均能发酵葡萄糖、乳糖、甘露醇和山梨醇,能产生β-半乳糖苷酶。个别菌株在蔗糖、麦芽糖、精氨酸、鸟氨酸、西门氏枸橼酸盐上的反应有所差异,仅1株菌可产硫化氢,但所有生化反应完全符合大肠杆菌的特性。
2类菌甘油阳性,硫化氢阴性,大部分菌株发酵蔗糖,少部分发酵蜜二糖和阿拉伯糖,符合粪肠球菌的生化特性。但所有菌株都能发酵葡萄糖这一指标与文献中判定为致病性粪肠球菌的指标不符,分离到的粪肠球菌可能不属于致病性粪肠球菌。
3类菌和4类菌奇异变形杆菌和鲍曼不动杆菌。图7
图7
图7
不同鸡场气管堵塞部位的细菌分离鉴定
Fig.7
Isolation and identification of bacteria in trachea blockage sites of different chicken farm
2.2 药敏
研究表明,样本中所有大肠杆菌株均对SMZ、TE、Amp表现出100%耐药,所有的粪肠球菌对AZT表现出100%耐药。表5
表5 大肠杆菌、粪肠球菌耐药情况统计
Table 5
| 抗菌药物 Antibacterials | 大肠杆菌耐药(R)(n=18) Drug resistance of Escherichia coil(R)(n=18) | 粪肠球菌耐药(R)(n=18) Drug resistance of Enterococcus faecalis(n=18) | ||
|---|---|---|---|---|
| 株数 Number of trees | 耐药率 Drug resistance rate(%) | 株数 Number of trees | 耐药率 Drug resistance rate(%) | |
| CTX | 17 | 94.4 | 15 | 83.3 |
| CAZ | 10 | 55.5 | 16 | 89.8 |
| AN | 5 | 28.7 | 11 | 61.1 |
| AZT | 7 | 39.8 | 18 | 100 |
| SMZ | 18 | 100 | 16 | 89.8 |
| CN | 6 | 33.3 | 5 | 28.7 |
| TE | 18 | 100 | 11 | 61.1 |
| Amp | 18 | 100 | 2 | 11.1 |
| CIP | 13 | 72.2 | 6 | 33.3 |
| LEV | 9 | 50.0 | 6 | 33.3 |
| CHL | 14 | 78.7 | 9 | 50.0 |
图8
图8
A-K鸡场大肠杆菌分离株对11种药物的耐药组合
Fig.8
Drug resistance combination of Escherichia coli isolates from chicken farm A-K to 11 drugs
图9
图9
A-K鸡场粪肠球菌分离株对11种药物的耐药组合
Fig.9
Drug resistance combination of E.faecalis isolates from chicken farm A-K to 11 drugs
2.3 小鼠致病性
将分离得到的菌株接种小白鼠,试验组小白鼠经腹腔注射菌液后均无明显的临床症状,无死亡现象;空白对照组无异常。
3 讨论
鸡支气管堵塞常常导致巨大经济的损失,采取生物安全防控和疫苗免疫在内的众多措施去预防此类疾病,但是这几年发病趋势不降反升[13]。研究者们普遍认为,支气管堵塞病变的形成是多因素的。在非细菌学方面,有研究证明新城疫能引起支气管的栓塞[15],禽流感9亚型也能引起相同的病变[16]。有研究证明,鼻气管鸟杆菌单独能引起三叉管堵塞病变[17]。许多研究表明了支原体、真菌均能引起鸡三叉管的堵塞。不同于实验室研究,在生产中很难遇到单一病原的疾病,许多研究者都假设有一些细菌性的致病菌也参与了该种病理变化的形成。研究对11个鸡场的18份样本进行了研究,结果从发病部位共分离到4种细菌,所有鸡场都有大肠杆菌和粪肠球菌,个别鸡场有奇异变形杆菌或鲍曼不动杆菌。这说明大肠杆菌和粪肠球菌的存在具有普遍性,与之前的许多研究结果相一致[18, 19]。并且许多报道都提及大肠杆菌和沙门氏菌的某些菌株可引发败血症、泌尿系统感染、继发性脑膜炎等症状[20, 21]。有些鸡场分离到了奇异变形杆菌或鲍曼不动杆菌,但无相关报道证明它们能引起禽类呼吸系统疾病,其是否参与鸡支气管堵塞形成方面的机理有待研究。
大肠杆菌和肠球菌普遍存在于鸡的肠道内,随粪便排出后会污染环境,是重要的条件致病菌,也是养鸡业的一大隐患。有学者证明,当低致病性病毒感染鸡后再接种低致病性大肠杆菌,比二者单独感染的致死率要高,并且气管接种大肠杆菌的主要表现为呼吸道的炎症反应[22]。当一些粉尘、病毒等损伤禽呼吸道气管粘膜的完整性后,菌体在呼吸道内迅速增殖,继而引发呼吸系统疾病[23]。新疆鸡养殖场的环境差、粉尘多,这可能会增加这些细菌的致病力。通过生化实验和小鼠致病性试验可知此次研究中分离的大肠杆菌和粪肠球菌不具有致病力,有报道也指出肠球菌很少出现单独感染,多是在与其它细菌协同下发生感染,并能增加患病动物的致死率和腹膜炎的发生率[24]。
大肠杆菌和粪肠球菌都是重要的耐药研究对象,近年来这2种菌的耐药问题日渐突出,耐药菌谱不断扩大,耐药程度也日趋严重。此次试验中大肠杆菌和粪肠球菌的耐药情况严重,其耐药性还存在明显的差异,其中大肠杆菌的耐药性比粪肠球菌要严重。曲志娜等[25]调查发现,有12种药物的耐药率在50%以上,其中对氨苄西林(87.21%)、四环素(86.99%)和复方新诺明(86.99%)的耐药率较高。11个鸡场的大肠杆菌对这3种药物的耐药率均达到了100%,所有菌株在此基础上搭配组合出了13种耐药谱型,以CTX、SMZ、TE、AMP、CIP、LEV、CHL这种耐药谱型较为常见,整体鸡源大肠杆菌呈现出的多重耐药问题严重且复杂多样。在养殖过程中应缓解该类抗生素的使用,并提倡联合用药。相比大肠杆菌,肠球菌具有更强的获得、表达和转移耐药性的能力[26]。选择相同药物进行粪肠球菌的药敏试验,发现粪肠球菌较大肠杆菌耐药情况较轻,仅对氨曲南表现出100%的耐药,大部分菌株对头孢他啶(89.8%)、复方新诺明(89.8%)、头孢噻肟(83.3%)耐药率较高,结果相比苏崴艺等[27]报道的耐药情况轻。F鸡场仅对氨基糖苷类药物表现出了耐药,该场可能存在氨基糖苷类药物滥用的情况[27, 28]。
4 结论
除了F鸡场、J鸡场2号和4号样本外,其余16株粪肠球菌都为多重耐药的粪肠球菌。同一样本中分离出的大肠杆菌和粪肠球菌对11种药物都表现出不同的耐药特点。大肠杆菌对CTX、SMZ、CN、TE、AMP、CIP、LEV和CHL的耐药性高于粪肠球菌,在临床上对于大肠杆菌感染经验应避免使用上述药物。CAZ、AN和AZT的耐药性大肠杆菌低于粪肠球菌,选用以上药物作为大肠杆菌的经验用药。
参考文献
肉鸡支气管阻塞的诊治
[J].
Diagnosis and treatment of bronchial obstruction in Broilers
[J].
一例蛋雏鸡因温度低引起的支气管堵塞的治疗
[J].
Treatment of bronchial obstruction caused by low temperature in an egg chicken
[J].
治疗鸡支气管干酪样物质阻塞的两种临床新措施
[J].
Two new clinical measures for treating cheese-like substance obstruction in chicken bronchi
[J].
一例商品蛋鸡气管堵塞的诊治
[J].
Diagnosis and treatment of tracheal obstruction in commercial laying hens
[J].
呼吸道病型H9亚型禽流感病毒的分离与鉴定
[J].
Isolation and identification of avian influenza virus subtype H9 of respiratory diseases
[J].
鸡支气管栓塞的临诊辨证与治疗
[J].
Clinic Diagnosis and Treatment of Chicken Bronchial Embolism
[J].
肉鸡支气管堵塞的病因分析及防治措施
[J].
Etiology analysis and prevention measures of bronchial obstruction in broilers
[J].
鸡呼吸道堵塞性疾病的综合防控
[J].
Comprehensive Prevention and Control of Chicken Respiratory Obstruction
[J].
肠出血性大肠杆菌EHECO157:H7的分子进化研究
[D].
Molecular Evolution of EHECO157:H7 of Enterohemorrhagic Escherichia coli
[D].
粪肠球菌PCR检测方法的建立
[J].
Establishment of a PCR assay for Enterococcus faecalis
[J].
Identification of and Composition Containing Polyphosphate Accumulating Bacteria
[J].
3种禽支原体多重PCR检测方法的建立及应用
[J].
establishment and application of multiple PCR for detection of mycoplasma avium in 3 species
[J].
肉鸡支气管堵塞并发大肠杆菌病的防治措施
[J].
Prevention and treatment of bronchial obstruction complicated with colibacillosis in broilers
[J].
Pathologic and Immunohistochemical Studies of Newcastle Disease (ND) in Broiler Chickens Vaccinated with ND: Severe Nonpurulent Encephalitis and Necrotizing Pancreatitis
[J].Twenty-five 22- to 46-day-old broilers with Newcastle disease (ND) were investigated pathologically and immunohistochemically in order to evaluate the mechanism of ND outbreak in vaccinated broilers. The broilers were vaccinated with ND live vaccine via drinking water. Clinical signs were neurologic and respiratory in nature. Macroscopically, bursal atrophy, white spots on the pancreas, and discoloration and enlargement of kidneys and spleen were observed in the broilers. Histologically, perivascular cuffing, neuronal degeneration and necrosis, and glial proliferation were present in the cerebrum, cerebellum, and medulla oblongata. There was extensive rarefaction and malacia in the parenchyma of severely affected brains. There were extensive degeneration, necrosis, and depletion of acinar cells in the pancreas. There was proliferation of macrophages in the lungs with congestion, tubulointerstitial nephritis, hepatocytic necrosis with thrombi in the sinusoids, and lymphocytic depletion in the cloacal bursa. Immunohistochemically, ND virus antigens were detected in the lesions. ND virus isolated from the present cases did not cause encephalitis or pancreatitis in specific-pathogen-free chickens, but it induced mortality with hepatocytic sinusoidal thrombi, splenic necrosis, lymphoid necrosis and depletion, and conjunctival hemorrhage. Severe nonpurulent encephalitis with extensive rarefaction and malacia, and necrotizing pancreatitis in the present case may suggest a close possibly causal relation with vaccination.
Co-infection of broilers with Ornithobacterium rhinotracheale and H9N2 avian influenza virus
[J].
大肠杆菌也是狠角色
[J].
Escherichia coli is also a strong role
[J].
两种粪肠球菌的分离纯化方法比较
[J].
Comparison of two isolation methods of Enterococcus faecalis
[J].
2002至2011年奇异变形杆菌的临床分布及药物敏感性变迁
[J].
Clinical distribution and drug sensitivity changes of Proteus mirabilis from 2002 to 2011
[J].
临床样本鲍曼氏不动杆菌检测及药敏试验结果分析
[J].
Detection of Acinetobacter baumannii in clinical samples and analysis of drug susceptibility test results
[J].
我国部分地区禽大肠杆菌病流行病学、免疫保护机理和与低致病禽流感病毒的致病协同
[D].
Epidemiology, immunoprotection mechanism and pathogenesis of low-pathogenic avian influenza virus in some areas of China
[D].
鸡大肠杆菌病的模型建立与中兽医辨证论治研究进展
[J].
Research progress of Chicken colibacillosis model establishment and syndrome differentiation and treatment of Chinese veterinary medicine
[J].
肠球菌感染的临床分布及耐药特征
[J].
Clinical distribution and drug resistance characteristics of enterococcal infection
[J].
不同省区鸡源大肠杆菌耐药性调查与系统进化群分析
[J].
Investigation of drug resistance and phylogenetic analysis of E. coli isolated from chickens in different provinces
[J].
Kneifel, Methods used for the isolation, enumeration, characterization and identification of Enterococcus spp. 2. Pheno- and genotypic criteria
[J].
某养殖场鸡源粪肠球菌分离鉴定及耐药性研究
[J].
Identification and Drug Resistance of Enterococcus faecalis from chicken in a farm
[J].